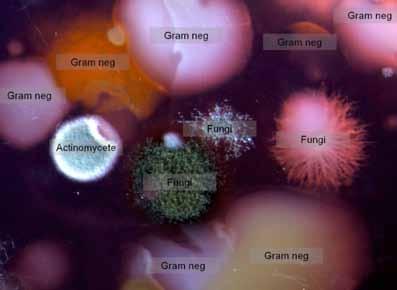

ACTINOMYCETEN SELECTEREN
Vorige week heb je grondmonsters uitgeplaat. Die zijn gaan groeien, en als alles goed gegaan is, heb je nu twee platen die behoorlijk overgroeid zijn met micro-organismen. De meeste van deze microorganismen zullen geen antibiotica produceren, maar sommige wel. Een klasse van bacteriën die daar bekend om staan zijn de actinomyceten. Deze actinomyceten ga je selecteren en testen op antibioticaproductie.
Herkennen van actinomyceten
Actinomyceten zijn lastig te herkennen voor een leek. De determinatietabel op pagina 10 helpt je bij het selecteren van actinomyceten voor het vervolg van het practicum. Begin linksboven in de determinatietabel bij stap 1. Hieronder staat een toelichting en afbeelding, behorend bij elke stap.
1. Hoe pluizig is de kolonie? Actinomyceten zijn zogenaamde filamenteuze bacteriën; ze vormen draden van aaneengeschakelde cellen, ofwel hyfen. Schimmels staan ook bekend om hun productie van hyfen het waarschijnlijk een schimmel. Hyfen van een actinomyceet kun je eigenlijk pas goed zien met een binoculair, een stereomicroscoop of met een digitale camera op macrostand.
Kijk ook naar de kleur: doorgaans zijn de actinomycetenkolonies wit, maar als je er een met een mooie kleur ziet, dan kun je er wel vanuit gaan dat het een actinomyceet is.
Afbeelding 1: actinomyceet in kleur en met pluis.

Herkennen van actinomyceten
Afbeelding 2: Pluizige actinomyceten, gezien door een stereomicroscoop.
2. Is de kolonie groot of klein, vergeleken met andere kolonies? De kolonies van actinomyceten zijn over het algemeen kleiner dan die van schimmels of Gram-negatieve bacteriën.

Afbeelding 3: Allerlei kolonies op een agarplaat (uitvergroting).
Actinomyceten groeien de agar in waardoor ze vastzitten in het medium. Als je er met een tandenstoker doorheen gaat, geeft dit weerstand en blijft de kolonie grotendeels intact. Ook zijn actinomyceten niet slijmerig, wat ze onderscheidt van de loszittende en slijmerige Gram-negatieve bacteriën.
Tot slot: sommige kolonies van actinomyceten lijken een beetje op puistjes of mee-eters; in het midden zie je een wit of donker puntje. Ook kun je soms een ring zien, zoals in de afbeelding hiernaast.
Afbeelding 4: Actinomyceet (werkelijke grootte ongever 5 mm)
Tip: bekijk meer fotovoorbeelden in de actinomyceten galerij op de website www.antibioticagezocht.nl (onder het kopje ‘in de klas’).

1
Kies een pluizige kolonie en let op de kleur: vaak is een actinomyceet wit, maar als je een kolonie ziet met veel pigmentatie (of een mooie kleur) is het waarschijnlijk een actinomyceet.
Hoe pluizig is de kolonie?
Een beetje pluizig, als je met een microscoop kijkt.
DETERMINATIETABEL ACTINOMYCEET
De kolonie is heel pluizig.
WAARSCHIJNLIJK IS DIT EEN SCHIMMEL…
De kolonie is niet pluizig.
De kolonie is groot.
2
Is de kolonie groot of klein, vergeleken met andere kolonies?
De kolonie is klein (<0,5 cm).
3
Zit de kolonie vast in de agar? Test dit door er met een tandenstoker tegenaan te duwen.
Nee, de kolonie zit los of is slijmerig.
Ja, de kolonie blijft zitten en blijft intact.
De kans bestaat dat je een actinomyceet hebt geselecteerd! Gebruik deze kolonie voor het vervolg van het practicum.
KIES EEN ANDERE KOLONIE EN BEGIN WEER BIJ VRAAG 1.
Selecteer in totaal vier kolonies. Geen kolonies meer over? Kijk bij je buren of vraag je docent of TOA om de plaat met de positieve controle.
WAARSCHIJNLIJK IS DIT EEN ANDERE BACTERIE…
